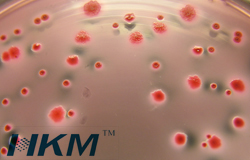
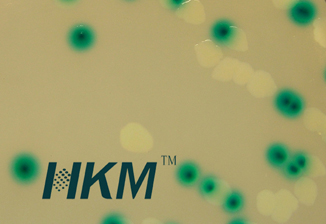

-

多联过滤器在饮料行业中微生物检测的应用
环凯牌MFS系列不锈钢过滤系统/多联过滤器/膜过滤器独特的专利“三爪式”扣具设计,不需要额外的夹具,便于单手操作和滤膜的取放,操作简单,使用效率更高,广泛应用于研究单位、检验检疫机构、质量监控机构、天然矿泉水行业
2014-11-10 -

婴幼儿配方食品中阪崎肠杆菌检验的解决方案(GB 4789.40-2010)
我公司针对目前乳制品行业及质量监测单位检验阪崎肠杆菌的需求及情况,对阪崎肠杆菌检验相应的培养基进行了改进,使得阪崎肠杆菌检出率较之前有很大的改进。扩充并完善了相关的微生物检测试剂,使得技术操作人员能更准确、快捷的检测出目标菌。
2014-11-07 -

食品中双歧杆菌检验的解决方案 GB 4789.34-2012
我公司针对目前乳制品行业及质量监测单位检验双歧杆菌的需求及情况,对双歧杆菌检验相应的培养基进行了改进,使得双歧杆菌检出率较之前有很大的改进。扩充并完善了相关的微生物检测试剂,使得技术操作人员能更准确、快捷的检测出目标菌。
2014-10-31 -

GB 4789.10-2010 食品安全国家标准 食品微生物学检验 第三法 金黄色葡萄球菌MPN计数 解决方案
我公司针对标准的修改,扩充完善了微生物检测试剂,推出了成套的金黄色葡萄球菌MPN计数解决方案,为生产企业提供方便。
2014-10-22 -

GB 4789.10-2010 食品安全国家标准 食品微生物学检验 第二法 金黄色葡萄球菌 Baird-Parker平板计数 解决方案
我公司针对标准的修改,扩充完善了微生物检测试剂,推出了成套的金黄色葡萄球菌 Baird-Parker平板计数解决方案,为生产企业提供方便。
2014-10-19 -
培养基配制好后为什么必须立即灭菌
大家都知道,培养基是供微生物生长、繁殖、代谢的混合养料。由于微生物具有不同的营养类型,对营养物质的要求也各不相同,加之实验和研究的目的不同,所以培养基的种类很多,使用的原料也各有差异。为了达到实验和研究的目的,要按照培养基的配方进行配制。
2014-08-04 -
培养基的灭菌方法
灭菌是指利用物理或化学法杀或除去物料及设备中一切有生命物质的过程。灭菌方法大致可分为物理方法和化学方法两种。物理方法主要有蒸汽(高温)、电磁波和辐照等方式,蒸汽灭菌属于经典式的灭菌方法
2014-08-01 -

微生物培养基配制与灭菌方法及步骤
微生物培养基是供微生物生长、繁殖、代谢的混合养料。由于微生物具有不同的营养类型,对营养物质的要求也各不相同,加之研究的目的不同,所以培养基的种类很多,使用的原料也各有差异
2014-06-27 -

食品中金黄色葡萄球菌检测
金黄色葡萄球菌 (Staphylococcus aureus ) 是人类的一种重要病原菌,隶属于葡萄球菌属(Staphylococcus),有“嗜肉菌"的别称,是革兰氏阳性菌的代表,可引起许多严重感染。
2014-06-20 -

火焰加热灭菌装置的注意事项
实验室中常用到的火焰加热或灼烧灭菌装置有酒精灯、本生灯和电子式火焰灭菌器。使用火焰加热灭菌装置的有哪些注意事项呢?
2014-05-30






